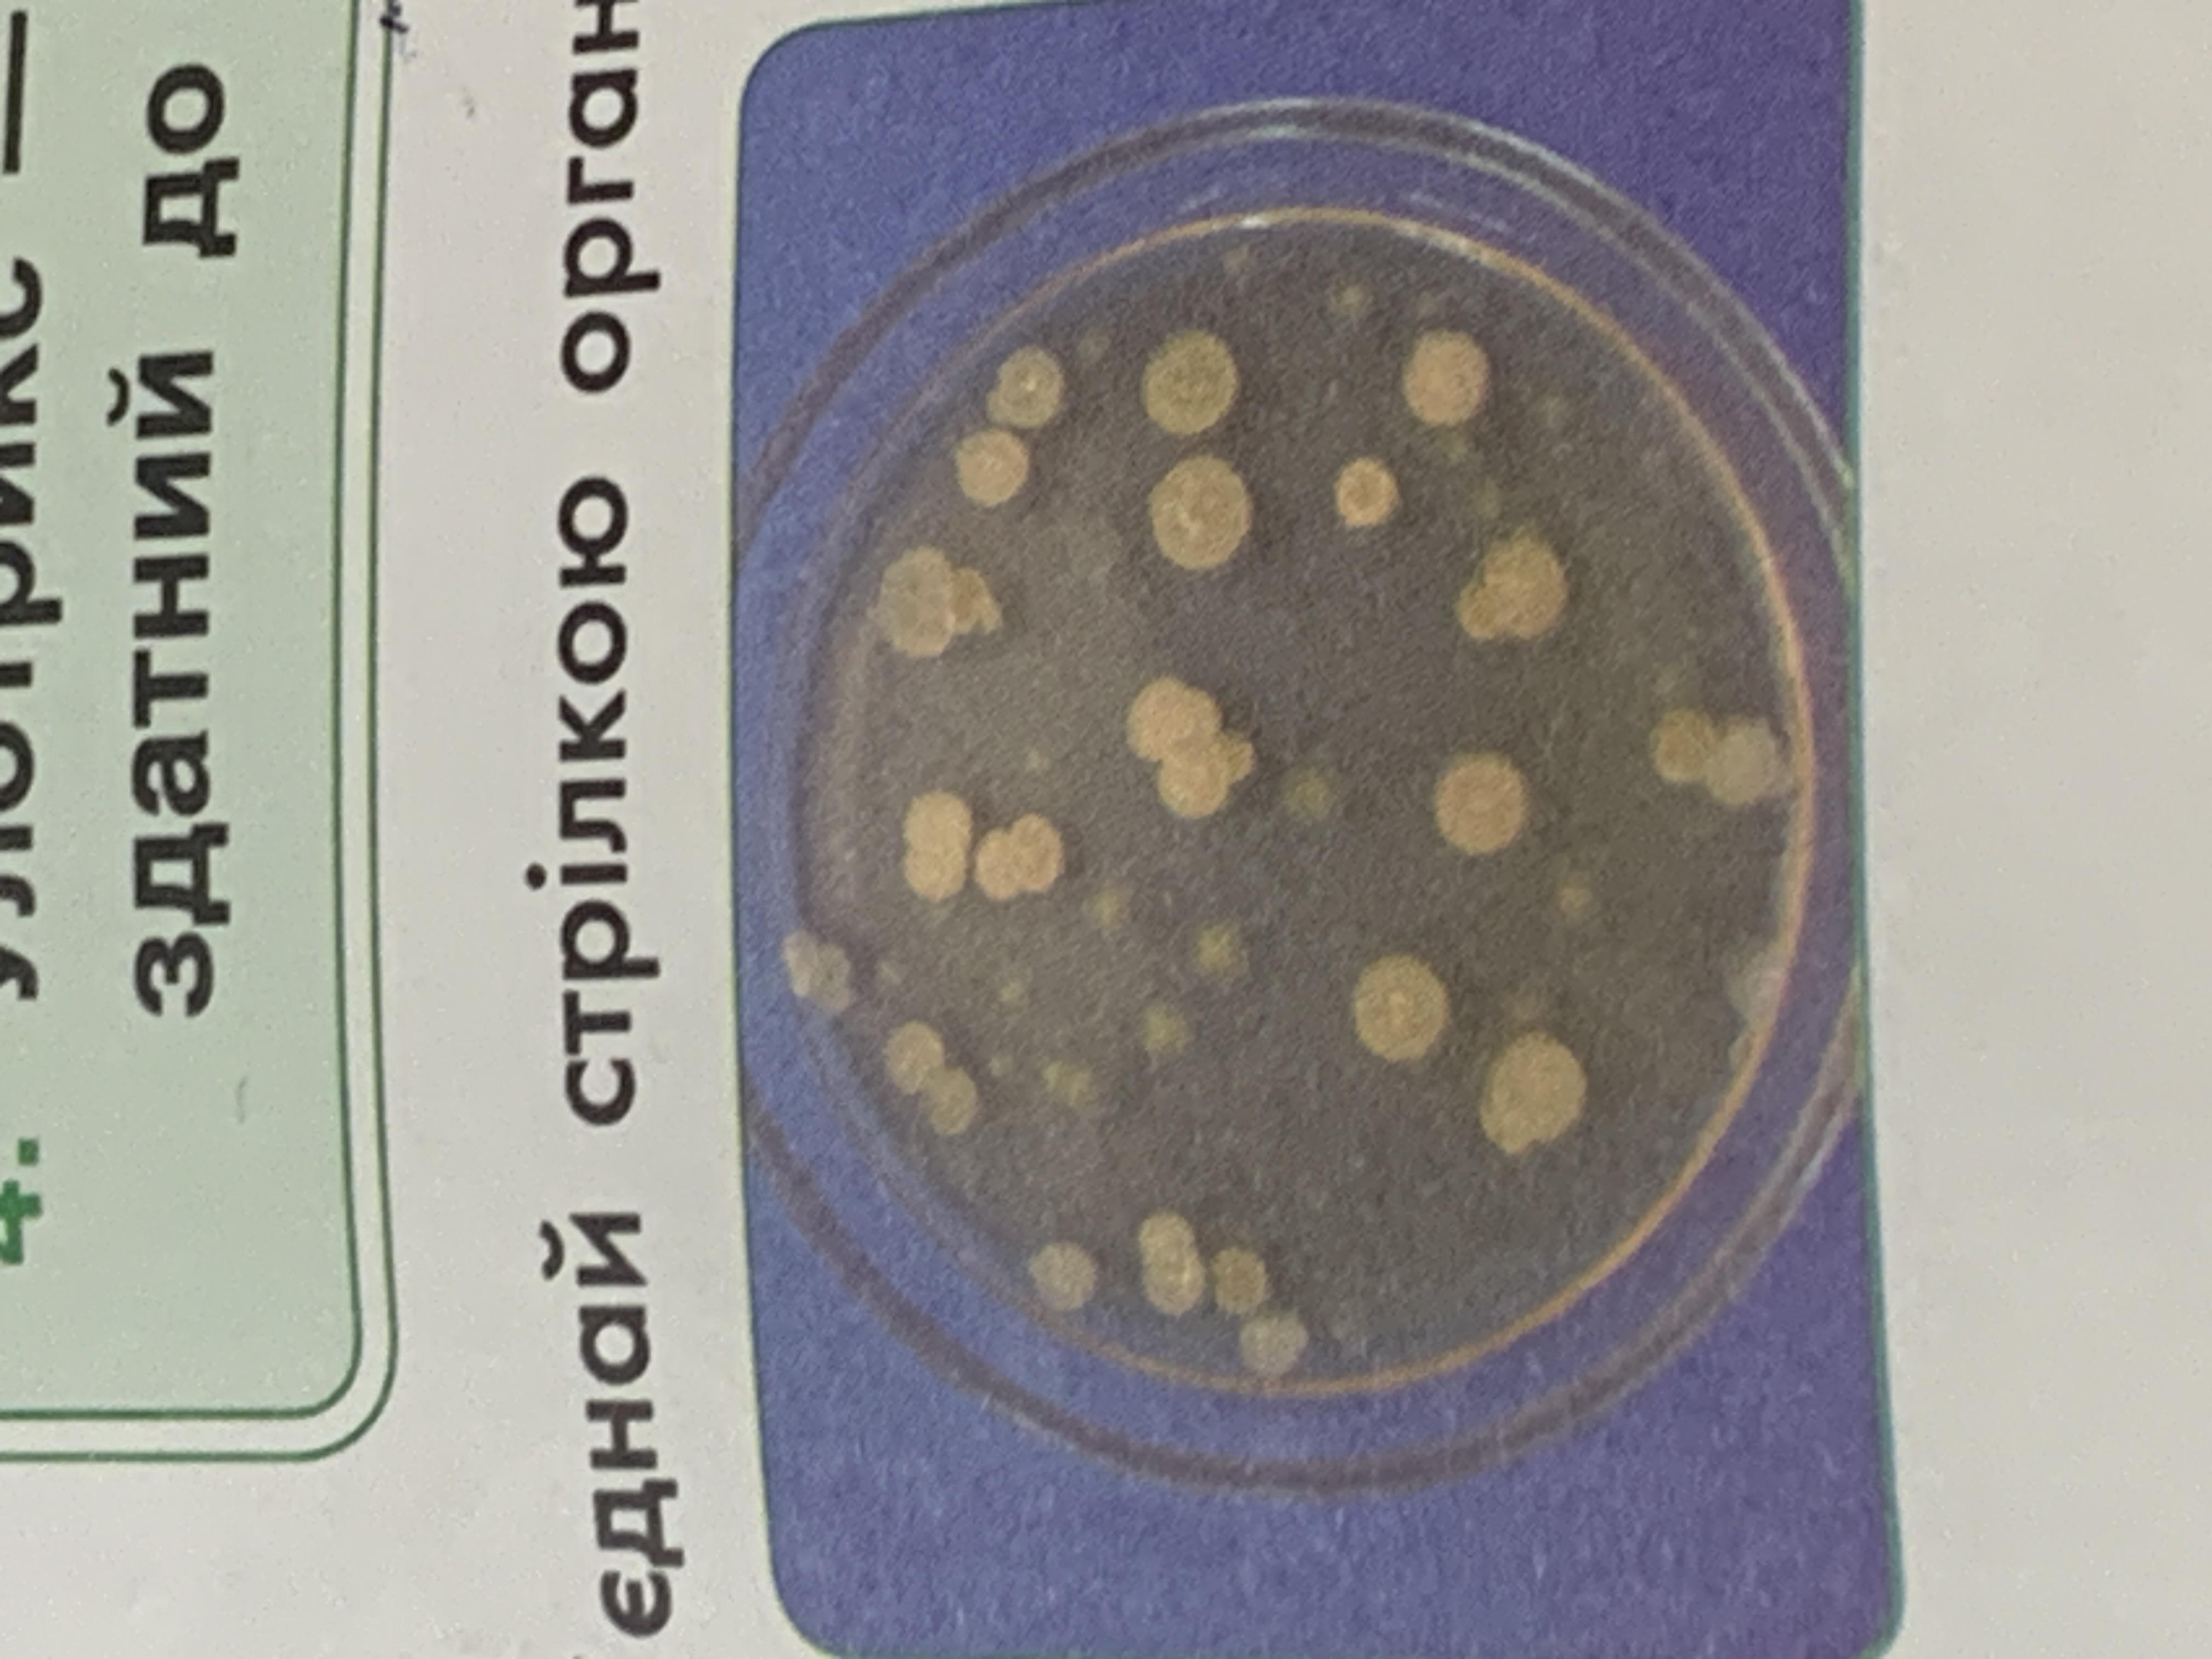

Предмет: Биология,
автор: tanyapylypiv10
Що забражено на малюнку? Колоніальні чи одноклітинні організми
Приложения:
Ответы
Автор ответа:
0
Ответ:
если я не ошибаюсь то колоніальні
Похожие вопросы
Предмет: Литература,
автор: NAZARVOLSKI
Предмет: Литература,
автор: valokkaka228008
Предмет: Алгебра,
автор: skonrad477
Предмет: Английский язык,
автор: luha85921
Предмет: Литература,
автор: Аноним